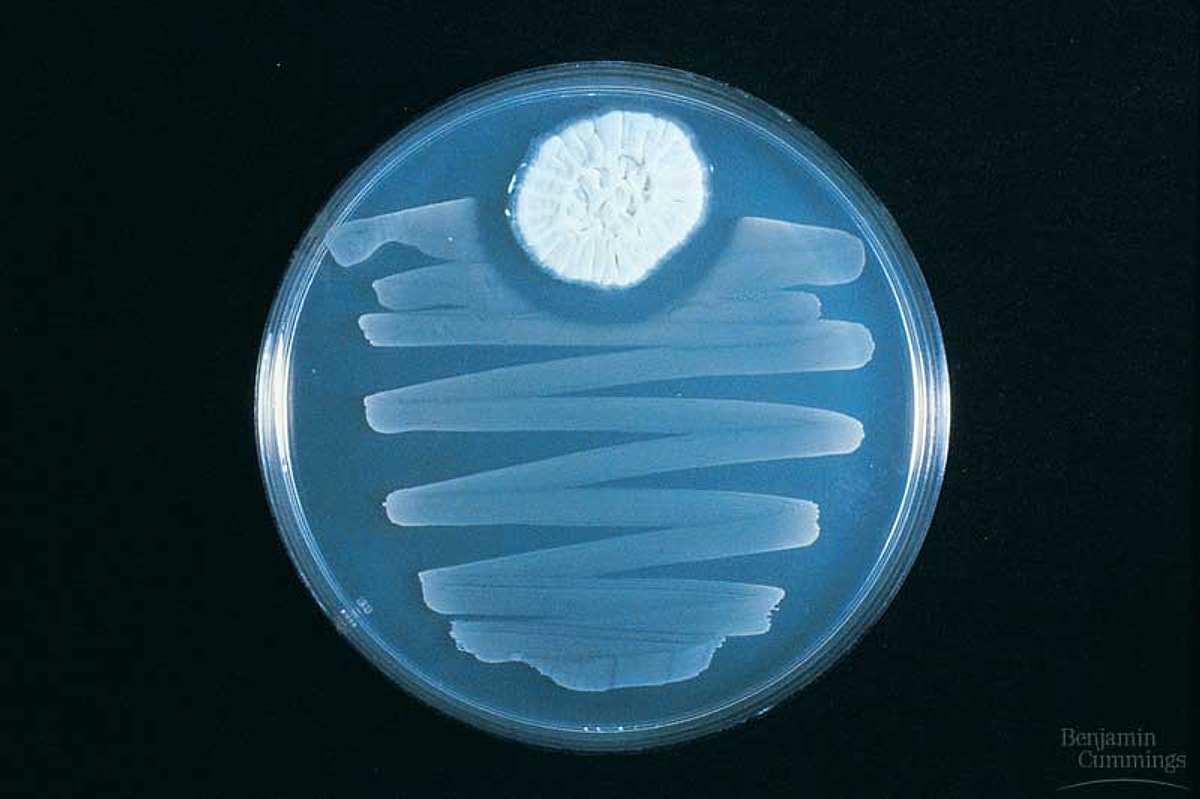

Как действует пенициллин на бактерии
Причинно следственные связи книги
Ино 11 класс ваулина
Фаиль фаттахович
Thinkpad 1 carbon
Журналистка г
Ремонты точка роста
Снять комнату длительно черкесск
Окр мир 1 класс созвездия
Как удалить приложения рутуб рутубе
Gorodfactov generator hamster
Родом из детства свои
Сверхлюди альянс
Kai rosenkranz
Как действует пенициллин на бактерии 116 фото